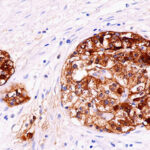

|
|---|
 Anti-Somatostatin Anti-SomatostatinBuy here |
 Anti-SOX10 Anti-SOX10Buy here |
 Anti-SOX2 Anti-SOX2Buy here |
 Anti-SOX2 Anti-SOX2Buy here |
 Anti-SOX2, Clone SOX2/1791 Anti-SOX2, Clone SOX2/1791Buy here |
 Anti-SOX9 [SOX9/2387] Anti-SOX9 [SOX9/2387]Buy here |
 Anti-SPARC (Osteonectin) Anti-SPARC (Osteonectin)Buy here |
 Anti-SSTR2 Anti-SSTR2Buy here |
 Anti-STAT-6 [EP325] Anti-STAT-6 [EP325]Buy here |
 Anti-STAT5 alpha Anti-STAT5 alphaBuy here |